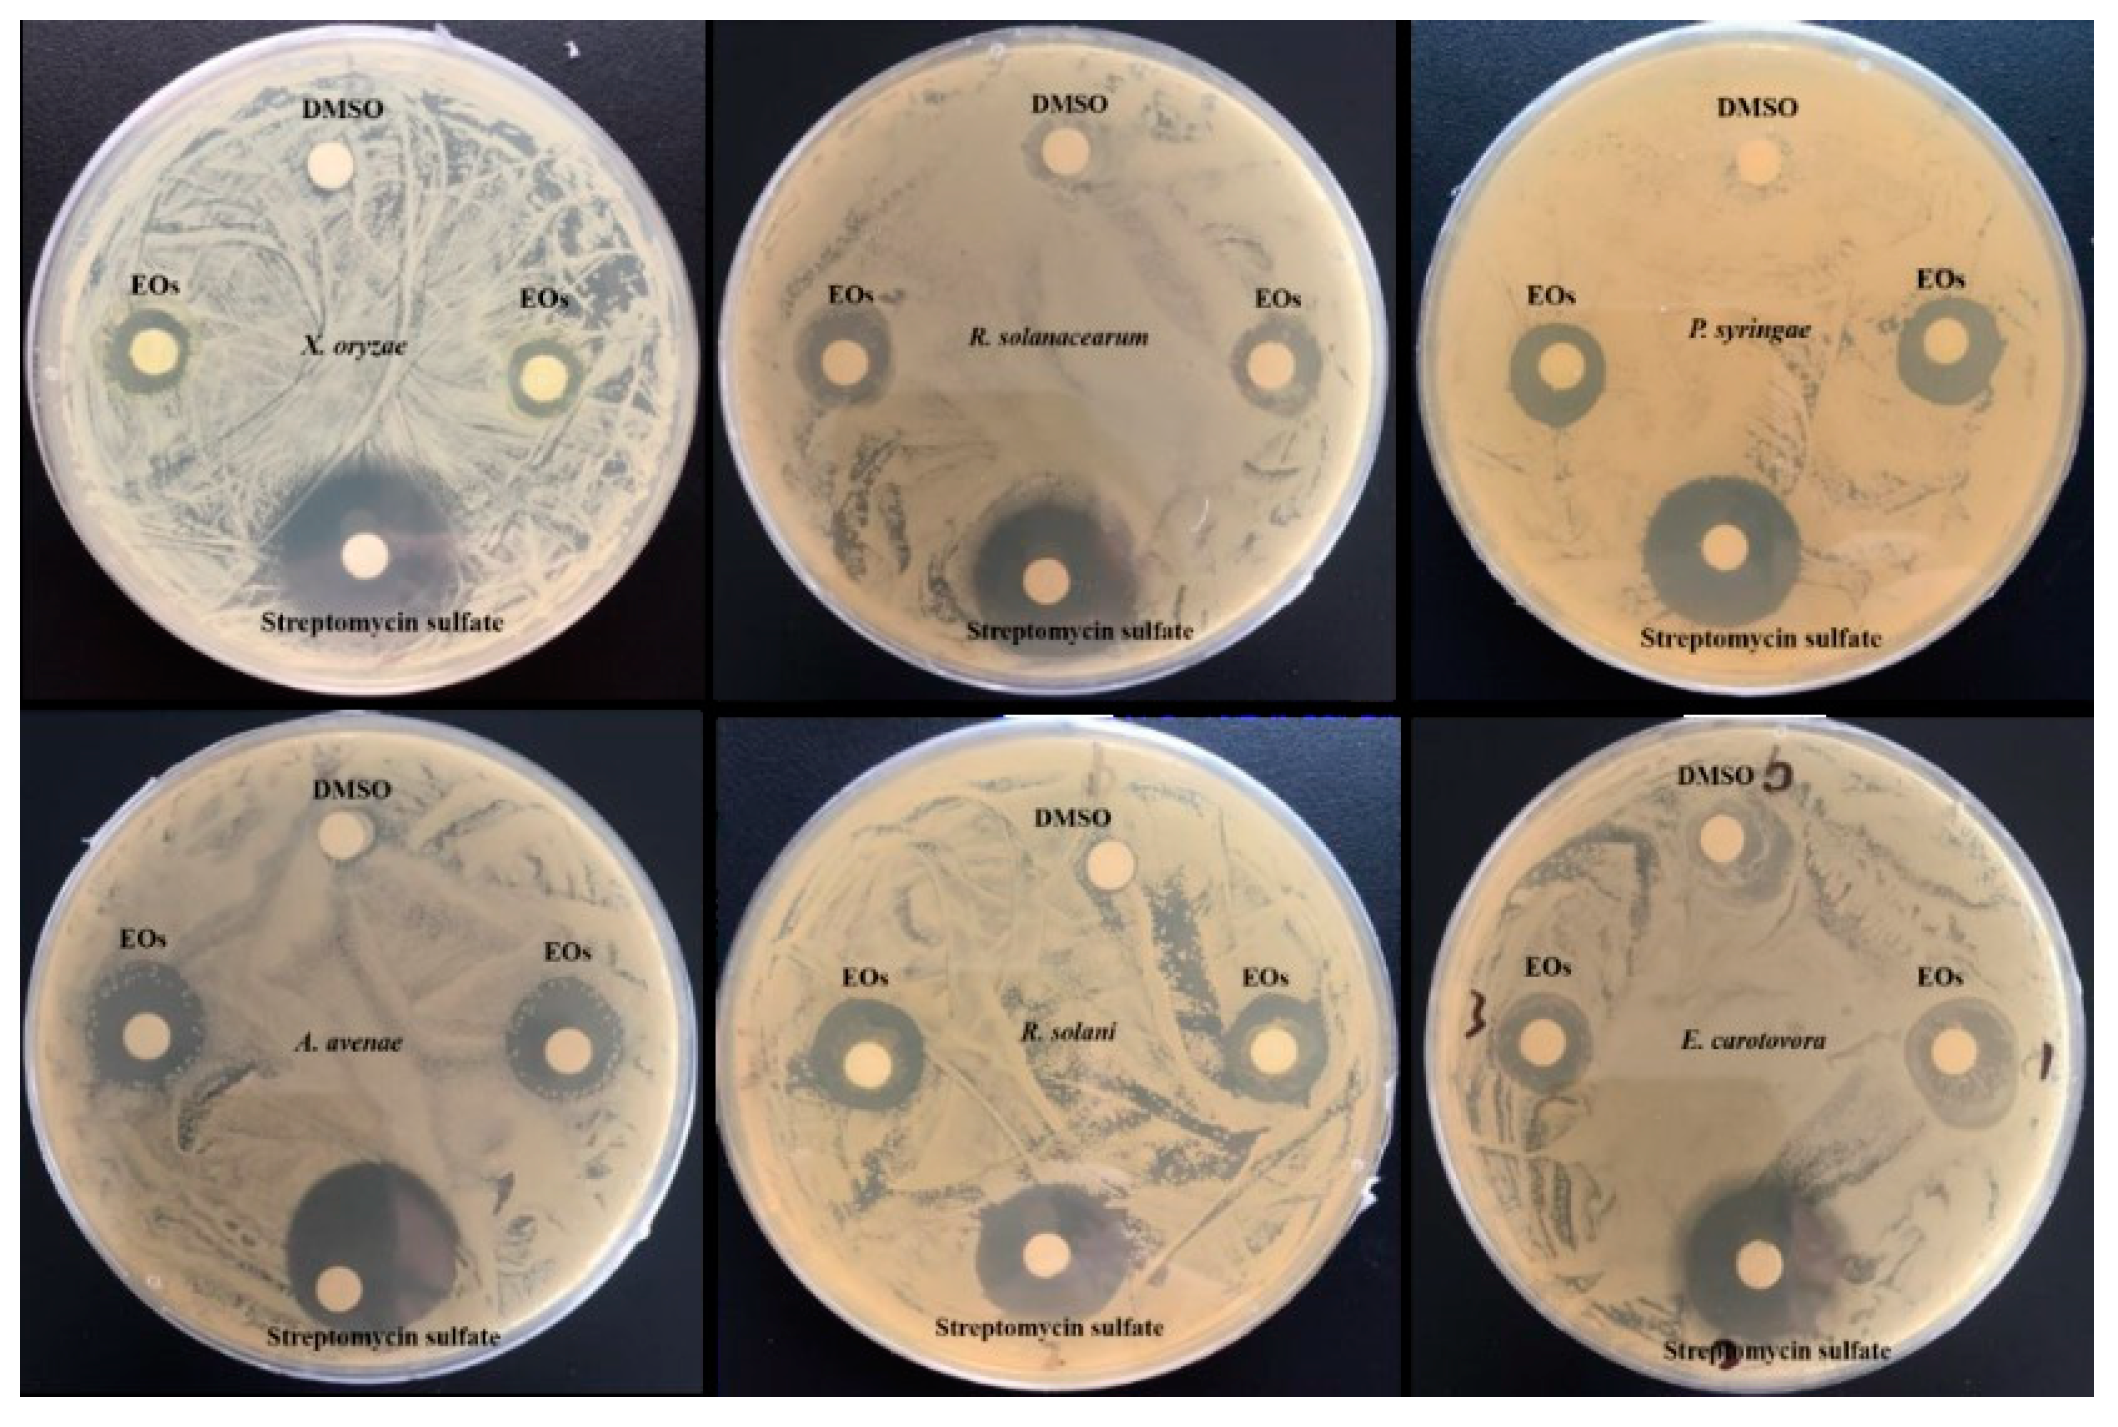
Biomolecules 09 00518 g003

Variation in Chemical Composition and Biological Activities of Flos Chrysanthemi indici Essential Oil under Different Extraction Methods
Abstract
1. Introduction
2. Materials and Methods
2.1. Plant Material and Chemicals
2.2. Extraction Method
2.2.1. Hydro-Distillation (HD)
2.2.2. Steam-Distillation Method (SD)
2.2.3. Solvent-Free Microwave Extraction (SFME)
2.2.4. Supercritical Fluid Extraction (SFE)
2.3. Gas Chromatography-Mass Spectrometry (GC–MS) Analysis
2.4. Antioxidant Capacity Evaluation
2.4.1. DPPH Radical-Scavenging Activity Assay
2.4.2. ABTS Radical Scavenging Activity
2.5. Evaluation of Antibacterial and Antifungal Activities
2.6. Determination of Minimum Inhibitory Concentration (MIC)
2.7. Scanning Electron Microscopy (SEM)
2.8. Data Analysis
3. Results and Discussion
3.1. Effect of Extraction Method on EO Yield
3.2. Effect of Extraction method on EOs Composition
3.3. Bioactivity of EOs
3.3.1. Antioxidant Activities
3.3.2. Antibacterial Activity
3.3.3. Antifungal Activity
4. Conclusions
Author Contributions
Funding
Conflicts of Interest
References
- Cheng, W.; Li, J.T.; Hu, C. Anti-inflammatory and immunomodulatory activities of the extracts from the inflorescence of Chrysanthemum indicum Linne. J. Ethnopharmacol. 2005, 101, 334. [Google Scholar] [CrossRef] [PubMed]
- Doyeon, L.; Goya, C.; Taesook, Y.; Myeongsook, C.; Byungkil, C.; Hokyoung, K. Anti-inflammatory activity of Chrysanthemum indicum extract in acute and chronic cutaneous inflammation. J. Ethnopharmacol. 2009, 123, 149–154. [Google Scholar]
- Wu, Q.; Deng, C.H.; Shen, S.; Song, G.X.; Hu, Y.M.; Fu, D.; Chen, J.K.; Zhang, X.M. Solid-phase microextraction followed by gas chromatography-mass spectrometry analysis of the volatile components of Flos Chrysanthemi indici in different growing areas. Chromatographia 2004, 59, 763–767. [Google Scholar] [CrossRef]
- Hashemi-Moghaddam, H.; Mohammadhosseini, M.; Basiri, M. Optimization of microwave assisted hydrodistillationon chemical compositions of the essential oils from the aerial parts of thymus pubescens and comparison with conventional hydrodistllation. J. Essent. Oil Bear Plants 2015, 18, 884–893. [Google Scholar] [CrossRef]
- Shrigod, N.M.; Swami Hulle, N.R.; Prasad, R.V. Supercritical fluid extraction of essential oil from mint leaves (Mentha spicata): Process optimization and its quality evaluation. J. Food Process Eng. 2017, 40, 1–9. [Google Scholar] [CrossRef]
- Asl, R.M.Z.; Niakousari, M.; Gahruie, H.H.; Saharkhiz, M.J.; Khaneghah, A.M. Study of two-stage ohmic hydro-extraction of essential oil from Artemisia aucheri Boiss.: Antioxidant and antimicrobial characteristics. Food Res. Int. 2018, 107, 462–469. [Google Scholar]
- Khalili, G.; Mazloomifar, A.; Larijani, K.; Tehrani, M.S.; Azar, P.A. Solvent-free microwave extraction of essential oils from Thymus vulgaris L. and Melissa officinalis L. Ind. Crops Prod. 2018, 119, 214–217. [Google Scholar] [CrossRef]
- Bajer, T.; Surmova, S.; Eisner, A.; Ventura, K.; Bajerova, P. Use of simultaneous distillation-extraction, supercritical fluid extraction and solid-phase microextraction for characterisation of the volatile profile of Dipteryx odorata (Aubl.) Willd. Ind. Crops Prod. 2018, 119, 313–321. [Google Scholar] [CrossRef]
- Khalvandi, M.; Amerian, M.; Pirdashti, H.; Keramati, S.; Hosseini, J. Essential oil of peppermint in symbiotic relationship with Piriformospora indica and methyl jasmonate application under saline condition. Ind. Crops Prod. 2019, 127, 195–202. [Google Scholar] [CrossRef]
- Barth, M.; Hankinson, T.R.; Zhuang, H.; Breidt, F. Microbiological spoilage of fruits and vegetables. Comp. Micro. Foods Bever. 2009, 135–183. [Google Scholar]
- Mansfield, J.; Genin, S.; Magori, S.; Citovsky, V.; Sriariyanum, M.; Ronald, P.; Toth, I.A.N. Top 10 plant pathogenic bacteria in molecular plant pathology. Mol. Plant Pathol. 2012, 13, 614–629. [Google Scholar] [CrossRef] [PubMed]
- Tian, Y.L.; Zhao, Y.Q.; Zhou, J.J.; Sun, T.; Luo, X.; Kurowski, C.; Hu, B.S.; Walcott, R.R. Prevalence of Acidovorax citrulli in commercial cucurbit seedlots during 2010–2018 in China. Plant Dis. 2019. [Google Scholar] [CrossRef]
- El Asbahani, A.; Miladi, K.; Badri, W.; Sala, M.; Aït Addi, E.H.; Casabianca, H.; El, M.A.; Hartmann, D.; Jilale, A.; Renaud, F.N. Essential oils: From extraction to encapsulation. Int. J. Pharm. 2015, 483, 220–243. [Google Scholar] [CrossRef] [PubMed]
- Baczek, K.B.; Kosakowska, O.; Przybyl, J.; Pioro-Jabrucka, E.; Costa, R.; Mondello, L.; Gniewosz, M.; Synowiec, A.; Weglarz, Z. Antibacterial and antioxidant activity of essential oils and extracts from costmary (Tanacetum balsamita L.) and tansy (Tanacetum vulgare L.). Ind. Crops Prod. 2017, 102, 154–163. [Google Scholar] [CrossRef]
- Hu, Y.; Zhang, J.; Kong, W.; Zhao, G.; Yang, M. Mechanisms of antifungal and anti-aflatoxigenic properties of essential oil derived from turmeric (Curcuma longa L.) on Aspergillus flavus. Food Chem. 2017, 220, 1–8. [Google Scholar] [CrossRef] [PubMed]
- Tao, N.; Jia, L.; Zhou, H. Anti-fungal activity of Citrus reticulata Blanco essential oil against Penicillium italicum and Penicillium digitatum. Food Chem. 2014, 153, 265–271. [Google Scholar] [CrossRef] [PubMed]
- Araújo, F.M.; Dantas, M.C.S.M.; Silva, L.S.E.; Aona, L.Y.S.; Tavares, I.F.; Souza-Neta, L.C.D. Antibacterial activity and chemical composition of the essential oil of Croton heliotropiifolius Kunth from Amargosa, Bahia, Brazil. Ind. Crops Prod. 2017, 105, 203–206. [Google Scholar] [CrossRef]
- Tzortzakis, N.G.; Economakis, C.D. Antifungal activity of lemongrass (Cympopogon citratus L.) essential oil against key postharvest pathogens. Innov. Food Sci. Emerg. 2007, 8, 253–258. [Google Scholar] [CrossRef]
- Ribes, S.; Fuentes, A.; Talens, P.; Barat, J.M. Use of oil-in-water emulsions to control fungal deterioration of strawberry jams. Food Chem. 2016, 211, 92–99. [Google Scholar] [CrossRef]
- Zhang, C.S.; Xin, H.; Zou, P. Plants at Beach in Shandong; Agricultural Science and Technology Press: Beijing, China, 2017. [Google Scholar]
- Sandrine, P.; Christian, G.; Giancarlo, C.; Farid, C. A comparison of essential oils obtained from lavandin via different extraction processes: Ultrasound, microwave, turbohydrodistillation, steam and hydrodistillation. J. Chromatogr. A 2013, 1305, 41–47. [Google Scholar]
- Memarzadeh, S.M.; Pirbalouti, A.G.; Adibnejad, M. Chemical composition and yield of essential oils from Bakhtiari savory (Satureja bachtiarica Bunge.) under different extraction methods. Ind. Crops Prod. 2015, 76, 809–816. [Google Scholar] [CrossRef]
- Jing, C.L.; Zhao, J.; Han, X.B.; Huang, R.H.; Cai, D.S.; Zhang, C.S. Essential oil of Syringa oblata Lindl. as a potential biocontrol agent against tobacco brown spot caused by Alternaria alternata. Crop Prot. 2018, 104, 41–46. [Google Scholar] [CrossRef]
- Babahmad, R.A.; Aghraz, A.; Boutafda, A.; Papazoglou, E.G.; Tarantilis, P.A.; Kanakis, C.; Hafidi, M.; Ouhdouch, Y.; Outzourhit, A.; Ouhammou, A. Chemical composition of essential oil of Jatropha curcas L. leaves and its antioxidant and antimicrobial activities. Ind. Crops Prod. 2018, 121, 405–410. [Google Scholar] [CrossRef]
- Clain, E.; Baranauskiene, R.; Kraujalis, P.; Sipailiene, A.; Mazdzieriene, R.; Kazernaviciute, R.; Kalamouni, C.E.; Venskutonis, P.R. Biorefining of Cymbopogon nardus from Reunion Island into essential oil and antioxidant fractions by conventional and high pressure extraction methods. Ind. Crops Prod. 2018, 126, 158–167. [Google Scholar] [CrossRef]
- Yangui, I.; Zouaoui Boutiti, M.; Boussaid, M.; Messaoud, C. Essential oils of Myrtaceae species growing wild in Tunisia: Chemical variability and antifungal activity against Biscogniauxia mediterranea, the causative agent of charcoal canker. Chem. Biodivers. 2017, 14, e1700058. [Google Scholar] [CrossRef] [PubMed]
- Gokhan, A. Composition and antibacterial effect on fodd borne pathogens of Hibiscus surrattensis L. calyces essential oil. Ind. Crops Prod. 2019, 137, 285–289. [Google Scholar]
- Jing, C.; Gou, J.; Han, X.; Wu, Q.; Zhang, C. In vitro and in vivo activities of eugenol against tobacco black shank caused by Phytophthora nicotianae. Pestic. Biochem. Phys. 2017, 142, 148–154. [Google Scholar] [CrossRef] [PubMed]
- Golmakani, M.T.; Rezaei, K. Comparison of microwave-assisted hydrodistillation with the traditional hydrodistillation method in the extraction of essential oils from Thymus vulgaris L. Food Chem. 2008, 109, 925–930. [Google Scholar] [CrossRef]
- Uquiche, E.; Cirano, N.; Millao, S. Supercritical fluid extraction of essential oil from Leptocarpha rivularis using CO2. Ind. Crops Prod. 2015, 77, 307–314. [Google Scholar] [CrossRef]
- Guan, W.; Li, S.; Yan, R.; Tang, S.; Quan, C. Comparison of essential oils of clove buds extracted with supercritical carbon dioxide and other three traditional extraction methods. Food Chem. 2007, 101, 1558–1564. [Google Scholar] [CrossRef]
- Gupta, A.; Naraniwal, M.; Kothari, V. Modern extraction methods for preparation of bioactive plant extracts. Int. J. Appl. Nat. Sci. 2012, 1, 8–26. [Google Scholar]
- Shen, S.; Sha, Y.; Deng, C.; Zhang, X.; Fu, D.; Chen, J. Quality assessment of Flos Chrysanthemi indici from different growing areas in China by solid-phase microextraction-gas chromatography-mass spectrometry. J. Chromatogr. A 2004, 1047, 281–287. [Google Scholar] [CrossRef]
- Chen, W.Y.; Vermaak, I.; Viljoen, A. Camphor-A fumigant during the black death and a coveted fragrant wood in ancient Egypt and Babylon—A review. Molecules 2013, 18, 5434–5454. [Google Scholar] [CrossRef] [PubMed]
- Kim, D.Y.; Won, K.J.; Hwang, D.I.; Park, S.M.; Kim, B.; Lee, H.M. Chemical composition, antioxidant and anti-melanogenic activities of essential oils from Chrysanthemum boreale Makino at Different Harvesting Stages. Chem. Biodivers. 2018, 15, e1700506. [Google Scholar] [CrossRef] [PubMed]
- Cui, H.; Bai, M.; Sun, Y.; Abdel-Samie, M.A.S.; Lin, L. Anbacterial activity and mechanism of Chuzhou chrysanthemum essential oil. J. Funct. Foods 2018, 48, 159–166. [Google Scholar] [CrossRef]
- Miguel, M.G. Antioxidant and anti-inflammatory activities of essential oils: A short review. Molecules 2010, 15, 9252–9287. [Google Scholar] [CrossRef] [PubMed]
- Abeer, A.M.; Said, I.B.; Hosny, A.Y.; Nader, A.A.; Mohamed, Z.M.S.; Ofelia, M.; Alberto, B. Antibacterial activity of three essential oils and some monoterpenes against Ralstonia solanacearum phylotypeⅡisolated from potato. Microb. Pathog. 2019, 135, 103604. [Google Scholar]
- Sabir, A.; EI-Khalfi, B.; Errachidi, F.; Chemsi, I.; Serrano, A.; Soukri, A. Evaluation of the potential of some essential oils in biological control against phytopathogenic agent Pseudomonas syringae pv. Tomato DC3000 responsible for the tomatoes speck. J. Plant Pathol. Microbiol. 2017, 8, 1000420. [Google Scholar]
- Castro, J.C.; Endo, E.H.; Souza, M.R.D.; Zanqueta, E.B.; Polonio, J.C.; Pamphile, J.A.; Ueda-Nakamura, T.; Nakamura, C.V.; Filho, B.P.D.; Filho, B.A.D.A. Bioactivity of essential oils in the control of Alternaria alternata in dragon fruit (Hylocereus undatus Haw.). Ind. Crops Prod. 2017, 97, 101–109. [Google Scholar] [CrossRef]

| No. | Name of Compound | Molecular Weight | CAS Number | Extraction Method a | |||||||
|---|---|---|---|---|---|---|---|---|---|---|---|
| HD | SD | SFME | SFE | ||||||||
| RT b | %A c | RT | %A | RT | %A | RT | %A | ||||
| 1 | Camphene | 136.125 | 000079-92-5 | 9.642 | 0.42 ± 0.05 | n.i | n.i | n.i | n.i | n.i | n.i |
| 2 | Eucalyptol | 154.136 | 000470-82-6 | 11.388 | 3.59 ± 1.64 | 11.418 | 11.38 ± 2.47 | 11.38 | 0.69 ± 0.04 | 11.38 | 0.95 ± 0.96 |
| 3 | 1,4-Cyclohexadiene, 1-methyl-4-(1-methylethyl)- | 136.125 | 000099-85-4 | 11.862 | 0.22 ± 0.05 | 11.862 | 0.28 ± 0.29 | n.i | n.i | n.i | n.i |
| 4 | Methyl ethyl cyclopentene | 110.11 | 019780-56-4 | n.i | n.i | n.i | n.i | 12.75 | 0.66 ± 0.21 | 12.746 | 0.66 ± 0.78 |
| 5 | (Z,Z)-3,5-Octadiene | 110.11 | 007348-80-3 | 12.754 | 1.45 ± 2.28 | 12.767 | 2.40 ± 0.47 | n.i | n.i | n.i | n.i |
| 6 | lsobenzofuranone | 182.094 | 054346-06-4 | 12.923 | 1.32 ± 0.47 | 12.936 | 1.97 ± 2.25 | 12.919 | 0.86 ± 0.98 | 12.923 | 0.57 ± 0.41 |
| 7 | (E)-2-Hexen-4-yn-1-ol | 96.058 | 053497-80-6 | 13.718 | 2.34 ± 1.12 | n.i | n.i | n.i | n.i | n.i | n.i |
| 8 | 1,7-Octadiene, 3,6-dimethylene | 134.11 | 003382-59-0 | n.i | n.i | n.i | n.i | 13.722 | 2.99 ± 0.74 | n.i | n.i |
| 9 | 4-Ethyl-2-hexynal | 124.089 | 071932-97-3 | n.i | n.i | 13.743 | 2.30 ± 0.87 | n.i | n.i | n.i | n.i |
| 10 | endo-Borneol | 154.136 | 000507-70-0 | n.i | n.i | n.i | n.i | n.i | n.i | 13.866 | 1.55 ± 0.06 |
| 11 | Borneol | 154.136 | 010385-78-1 | 13.909 | 7.07 ± 1.17 | 13.925 | 5.22 ± 2.74 | 13.913 | 8.01 ± 2.44 | n.i | n.i |
| 12 | 4-methyl-1-(1-methylethyl)-3-Cyclohexen-1-ol | 154.136 | 000562-74-3 | n.i | n.i | 14.018 | 1.20 ± 0.24 | n.i | n.i | n.i | n.i |
| 13 | 1-butenylidene-Cyclohexane | 136.125 | 036144-40-8 | 14.234 | 1.05 ± 0.25 | n.i | n.i | 14.234 | 0.96 ± 0.47 | n.i | n.i |
| 14 | heptenol | 194.131 | 1000195-66-0 | 14.746 | 17.99±1.25 | n.i | n.i | 14.746 | 16.66±2.31 | 14.716 | 6.93± 0.09 |
| 15 | tert-butyl-Benzene | 134.11 | 000098-06-6 | n.i | n.i | 15.13 | 24.12±2.36 | 14.746 | 0.15 ± 0.47 | n.i | n.i |
| 16 | Bicyclo[3.1.1]hept-2-en-6-ol, 2,7,7-trimethyl-, acetate, [1S-(1. 1α,5α,6β)]- | 194.131 | 050764-55-1 | n.i | n.i | n.i | n.i | 15.122 | 1.71 ± 1.21 | n.i | n.i |
| 17 | Bornyl acetate | 196.146 | 000076-49-3 | 15.545 | 2.06 ± 0.04 | 15.558 | 3.15 ± 2.14 | 15.545 | 1.33 ± 0.05 | 15.537 | 1.51 ± 0.23 |
| 18 | Cosmene | 134.11 | 000460-01-5 | 16.074 | 0.28 ± 0.06 | 16.078 | 0.26 ± 0.12 | n.i | n.i | n.i | n.i |
| 19 | Caryophyllene | 204.188 | 000087-44-5 | n.i | n.i | 17.473 | 0.43 ± 0.25 | n.i | n.i | 17.469 | 0.31 ± 0.01 |
| 20 | Isocaryophyllene | 204.188 | 000118-65-0 | n.i | n.i | n.i | n.i | n.i | n.i | 17.765 | 0.68 ± 0.99 |
| 21 | a-Gurjunene | 204.188 | 000489-40-7 | 18.137 | 0.27 ± 0.01 | n.i | n.i | 18.137 | 0.28 ± 0.04 | n.i | n.i |
| 22 | Curcumene | 202.172 | 000644-30-4 | 18.179 | 0.58 ± 0.11 | n.i | n.i | 18.184 | 0.84 ± 0.31 | 18.175 | 0.33 ± 0.11 |
| 23 | Naphthalene | 204.188 | 000473-13-2 | 18.37 | 1.28 ± 0.25 | n.i | n.i | 18.441 | 3.26 ± 1.02 | 18.366 | 0.21 ± 0.14 |
| 24 | Spathulenol | 204.188 | 025246-27-9 | n.i | n.i | n.i | n.i | 18.37 | 1.12 ± 0.08 | n.i | n.i |
| 25 | 1,1,7-Trimethyl-4-methylenedec ahydro-1H-cyclopropa[e]azulene | 204.188 | 025246-27-9 | 18.37 | 0.53 ± 0.25 | n.i | n.i | 18.37 | 1.49 ± 0.79 | n.i | n.i |
| 26 | trans-β-Farnesene | 204.188 | 018794-84-8 | 18.251 | 2.66 ± 0.17 | 18.725 | 0.33 ± 0.45 | 20.213 | 5.07 ± 2.14 | n.i | n.i |
| 27 | (Z)-3-Undecen-1-yne | 150.141 | 074744-32-4 | n.i | n.i | n.i | n.i | n.i | n.i | 19.528 | 1.23 ± 0.28 |
| 28 | Caryophyllene oxide | 220.183 | 001139-30-6 | 19.541 | 4.23 ± 1.11 | 19.537 | 1.09 ± 0.52 | 19.554 | 7.33 ± 1.28 | n.i | n.i |
| 29 | (E,Z)-α-Famesene | 204.188 | 1000293-03-2 | n.i | n.i | n.i | n.i | 20.213 | 1.0 ± 0.04 | n.i | n.i |
| 30 | 1R,3Z,9S-4,11,11-Trimethyl-8-methylenebicyclo [7.2.0] undec-3-ene | 204.188 | 1000140-07-3 | 20.416 | 1.35 ± 0.28 | n.i | n.i | n.i | n.i | n.i | n.i |
| 31 | cis-Z-α-Bisabolene epoxide | 220.183 | 1000131-71-2 | 20.501 | 0.49 ± 0.74 | n.i | n.i | n.i | n.i | 20.818 | 0.39 ± 0.08 |
| 32 | trans-α-Bergamotene | 204.188 | 013474-59-4 | 20.97 | 3.76 ± 0.45 | n.i | n.i | n.i | n.i | n.i | n.i |
| 33 | 2,6-dimethyl-6-(4-methyl-3-pentenyl)-Bicyclo [3.1.1] hept-2-ene | 204.188 | 017699-05-7 | n.i | n.i | n.i | n.i | 20.974 | 4.98 ± 2.47 | n.i | n.i |
| 34 | 1,3-Bis-(2-cyclopropyl, 2-methylcyclopropyl)-but-2-en-1-one | 258.198 | 1000222-08-6 | n.i | n.i | n.i | n.i | n.i | n.i | 20.975 | 1.31± 0.04 |
| 35 | 1,7,7-Trimethylbicyclo [2.2.1] hept-5-en-2-one | 150.104 | 022516-10-5 | 21.288 | 5.89 ± 0.87 | 21.266 | 0.67 ± 0.12 | 21.296 | 8.18 ± 2.14 | 21.262 | 3.90 ± 1.25 |
| 36 | Camphor | 150.104 | 022516-10-5 | 21.288 | 23.53±5.21 | 21.266 | 39.71±2.89 | 21.296 | 13.51±1.57 | 21.262 | 7.14 ± 2.36 |
| 37 | Naphthalenone | 218.167 | 091416-23-8 | 21.381 | 1.59 ± 0.21 | n.i | n.i | 1.34 ± 0.51 | n.i | n.i | |
| 38 | 6,6-Dimethyl-2-vinylidenebicyclo [3.1.1] heptane | 148.125 | 039021-75-5 | n.i | n.i | n.i | n.i | 21.389 | 2.31 ± 0.58 | n.i | n.i |
| 39 | 5-benzyloxy-Pent-1-yne | 174.104 | 057618-47-0 | 21.609 | 1.27 ± 0.28 | n.i | n.i | n.i | n.i | n.i | n.i |
| 40 | octahydro-1,4,9,9-tetramethyl-1H -3a, 7-Methanoazulene | 206.203 | 025491-20-7 | 21.93 | 0.34 ± 0.14 | n.i | n.i | 21.93 | 1.05 ± 0.43 | 21.93 | 0.22 ± 0.08 |
| 41 | 1,5-Heptadiyne | 92.063 | 000764-56-7 | n.i | n.i | n.i | n.i | n.i | n.i | 22.07 | 1.06 ± 0.41 |
| 42 | Phenylethyne | 102.047 | 000536-74-3 | n.i | n.i | n.i | n.i | n.i | n.i | 23.152 | 0.25 ± 0.09 |
| 43 | 2,3-dihydroxy-1H-Cyclopenta[b] quinoxalin-1-one | 214.038 | 023774-23-4 | 23.512 | 1.34 ± 0.96 | n.i | n.i | 23.512 | 4.76 ± 1.12 | 23.512 | 7.63 ± 1.25 |
| 44 | 2,3,4,5-tetramethyl-Tricyclo [3.2.1.02,7] oct-3-ene | 162.141 | 062338-44-7 | n.i | n.i | n.i | n.i | n.i | n.i | 23.668 | 7.62 ± 1.47 |
| 45 | Octacosane | 394.454 | 000630-02-4 | n.i | n.i | n.i | n.i | n.i | n.i | 24.789 | 1.81 ± 0.21 |
| 46 | Heneicosane | 296.344 | 000629-94-7 | 24.793 | 0.81 ± 0.22 | n.i | n.i | 24.793 | 1.10 ± 0.17 | n.i | n.i |
| 47 | Linoleic acid | 294.256 | 002566-97-4 | n.i | n.i | n.i | n.i | 24.729 | ± 0.03 | 25.106 | 2.22 ± 0.09 |
| 48 | 7,10,13-Hexadecatrienoic acid, methyl ester | 264.209 | 056554-30-4 | n.i | n.i | n.i | n.i | n.i | n.i | 25.161 | 3.45 ± 1.12 |
| 49 | Cyclododecyne | 164.157 | 001129-90-4 | 25.313 | 0.56 ± 0.12 | n.i | n.i | n.i | n.i | 25.313 | 1.75 ± 0.25 |
| 50 | Tricosane | 324.376 | 000638-67-5 | 26.569 | 0.96 ± 0.08 | n.i | n.i | 26.573 | 1.25 ± 0.21 | 26.573 | 4.03 ± 1.25 |
| 51 | 1-(2,2-dimethyl-1-phenylethynylcyclopropyl)-Ethanol | 214.136 | 1000268-53-7 | n.i | n.i | n.i | n.i | n.i | n.i | 26.641 | 5.31± 0.14 |
| 52 | Acetic acid, 9,9-dioxo-9-thiabicyclo [3.3.1] non-6-en-2-yl ester | 230.061 | 1000185-79-6 | n.i | n.i | n.i | n.i | n.i | n.i | 27.005 | 2.86 ± 0.89 |
| 53 | Pentacosane | 352.407 | 000629-99-2 | 28.206 | 0.34 ± 0.08 | n.i | n.i | 28.205 | 0.45 ± 0.22 | 28.206 | 4.56 ± 1.12 |
| 54 | 2-Hexenedioic acid, 2-methoxy-, dimethyl ester | 202.084 | 056114-71-7 | n.i | n.i | n.i | n.i | n.i | n.i | 28.903 | 1.06 ± 0.95 |
| 55 | l-Cysteine, N,S-bis (cyclohexylcarbonyl)-, methyl ester | 355.182 | 1000282-52-4 | n.i | n.i | n.i | n.i | n.i | n.i | 29.254 | 1.26 ± 0.02 |
| 56 | Hentriacontane | 436.501 | 000630-04-6 | n.i | n.i | n.i | n.i | n.i | n.i | 29.719 | 1.10 ± 0.29 |
| 57 | Eicosane | 282.329 | 000112-95-8 | n.i | n.i | n.i | n.i | n.i | n.i | 31.132 | 0.73 ± 0.28 |
| 58 | 4-Trimethyl-3-hydroxymethyl-5a-(3-methyl-but-2-enyl)-cyclhexene | 222.198 | 1000144-10-5 | 32.185 | 1.79 ± 0.74 | n.i | n.i | n.i | n.i | n.i | n.i |
| 59 | Ursodeoxycholic acid | 392.293 | 000128-13-2 | n.i | n.i | n.i | n.i | n.i | n.i | 35.504 | 0.55± 0.25 |
| 60 | Chola-5,22-dien-3-ol, (3. β.,22Z)- | 342.292 | 057597-14-5 | n.i | n.i | n.i | n.i | n.i | n.i | 35.656 | 1.82 ± 0.87 |
| Samples | IC50 (mg/mL) | |
|---|---|---|
| DPPH | ABTS | |
| Ascorbic acid | 0.08 ± 0.01a | 0.12 ± 0.02 a |
| HD | 0.53 ± 0.03 c | 1.14 ± 0.08 c |
| SD | 0.58 ± 0.05 c | 0.84 ± 0.07 b |
| SFME | 0.43 ± 0.01 b | 0.75 ± 0.03 b |
| SFE | 0.42 ± 0.03 b | 1.05 ± 0.11 c |
| Method | MIC (µg/mL) | |||||
|---|---|---|---|---|---|---|
| X. oryzae | R. solanacearum | P. syringae | A. avenae | R. solani | E. carotovora | |
| Positive control | 0.1 | 25.0 | 20.0 | 2.50 | -- | 1.95 |
| HD | 62.5 | 125.0 | 62.5 | 62.5 | 125.0 | 125.0 |
| SD | 125.0 | 125.0 | 62.5 | 125.0 | 125.0 | 125.0 |
| SFME | 62.5 | 125.0 | 62.5 | 62.5 | 125.0 | 62.5 |
| SFE | 62.5 | 62.5 | 62.5 | 125 | 125.0 | 62.5 |
© 2019 by the authors. Licensee MDPI, Basel, Switzerland. This article is an open access article distributed under the terms and conditions of the Creative Commons Attribution (CC BY) license (http://creativecommons.org/licenses/by/4.0/).
Share and Cite
Jing, C.-L.; Huang, R.-H.; Su, Y.; Li, Y.-Q.; Zhang, C.-S. Variation in Chemical Composition and Biological Activities of Flos Chrysanthemi indici Essential Oil under Different Extraction Methods. Biomolecules 2019, 9, 518. https://doi.org/10.3390/biom9100518
Jing C-L, Huang R-H, Su Y, Li Y-Q, Zhang C-S. Variation in Chemical Composition and Biological Activities of Flos Chrysanthemi indici Essential Oil under Different Extraction Methods. Biomolecules. 2019; 9(10):518. https://doi.org/10.3390/biom9100518
Chicago/Turabian StyleJing, Chang-Liang, Rui-Huan Huang, Yan Su, Yi-Qiang Li, and Cheng-Sheng Zhang. 2019. "Variation in Chemical Composition and Biological Activities of Flos Chrysanthemi indici Essential Oil under Different Extraction Methods" Biomolecules 9, no. 10: 518. https://doi.org/10.3390/biom9100518
APA StyleJing, C.-L., Huang, R.-H., Su, Y., Li, Y.-Q., & Zhang, C.-S. (2019). Variation in Chemical Composition and Biological Activities of Flos Chrysanthemi indici Essential Oil under Different Extraction Methods. Biomolecules, 9(10), 518. https://doi.org/10.3390/biom9100518





